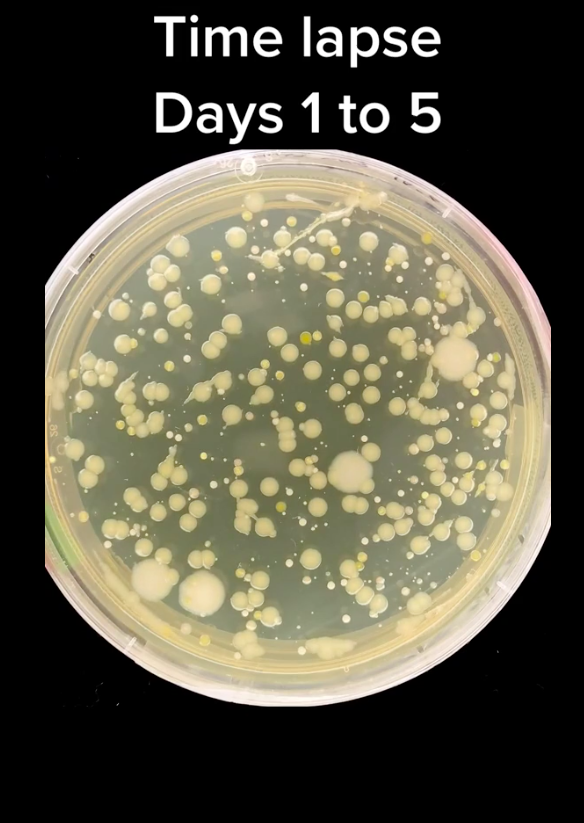
Thứ trong nhà bẩn hơn bồn cầu nhiều lần nhưng không phải ai cũng biết làm sạch đúng cách-2

Bồn rửa nhà bếp - nơi ẩn náu vi khuẩn nhiều nhất
Khi nhắc đến nơi bẩn nhất trong nhà, nhiều người sẽ nghĩ ngay đến bồn cầu - nơi ẩm ướt và thường tiếp xúc với chất thải. Nhưng thực tế, bồn rửa nhà bếp mới thực sự là thứ "bẩn", đồng thời tiềm ẩn nhiều nguy cơ lan truyền vi khuẩn nhất.
Theo Tiến sĩ Charles Gerba, nhà vi trùng học và giáo sư tại Đại học Arizona (Mỹ): "Bồn rửa nhà bếp là nơi chứa đầy vi trùng. Thử nghĩ mà xem, bạn đổ mọi thứ vào nó. Bạn thái thịt sống sau đó rửa sạch thớt trong bồn rửa. Bạn đổ đồ ăn thừa vào bồn rửa. Bạn rã đông các loại thịt đông lạnh hoặc rửa gà sống. Đó là lý do vì sao có nhiều vi khuẩn trong bồn rửa hơn cả trong bồn cầu".

Có nhiều vi khuẩn trong bồn rửa hơn cả trong bồn cầu.
Ngoài thực phẩm, thì miếng giẻ rửa bát cũng có thể là nguyên nhân gây nhiễm khuẩn cho bồn rửa. Vị tiến sĩ nói, có đến 10 triệu vi khuẩn trên mỗi inch vuông (1 inch = 2,54cm) của miếng giẻ bằng mút, và khoảng một triệu con nếu miếng giẻ bằng vải. Thậm chí, miếng giẻ rửa bát còn bẩn gấp 200.000 lần bồn cầu.
Khi bạn dùng những miếng giẻ rửa bát này để lau chùi bồn rửa, chúng sẽ gieo rắc vi khuẩn nhiều hơn nữa. Trong bồn rửa, có thể chứa các vi khuẩn gây bệnh truyền qua thực phẩm, phổ biến nhất là Campylobacter jejuni, Salmonella và Escherichia coli. Những vi khuẩn này có thể gây buồn nôn, nôn mửa, tiêu chảy, sốt và các biểu hiện ngộ độc thực phẩm khác sau khi xâm nhập vào cơ thể người.
Đáng nói, bồn rửa thường được các gia đình sử dụng để ngâm rửa rau, hoặc đựng thực phẩm sống trước khi chế biến.
Thử nghiệm rùng mình chứng minh dùng xà phòng + nước nóng cũng không thể tiêu diệt hết vi khuẩn trong bồn rửa bát
Để làm sạch bồn rửa của gia đình, hầu hết chúng ta đều cọ sạch với xà phòng, sau đó rửa lại bằng nước nóng - Vậy là đủ yên tâm cho quy trình "diệt khuẩn". Tuy nhiên thử nghiệm dưới đây trên kính hiển vi sẽ khiến bạn phải suy nghĩ lại về độ sạch sẽ của bồn rửa nhà mình.
Đây là một video đang "gây bão" trên mạng xã hội Tiktok của tài khoản có tên What Might Grow. Theo đó, tác giả đã thử nghiệm cho đồ ăn vào bồn rửa, sau đó rửa sạch bằng nước thường. Sau khi lấy mẫu nước trong bồn và soi dưới kính hiển vi, người này phát hiện một số lượng vi khuẩn rất lớn.
Thử nghiệm chứng minh dùng xà phòng + nước nóng cũng không thể tiêu diệt hết vi khuẩn.
Ở cách thứ hai, tác giả đã đổ xà phòng vào bồn rửa rồi tiến hành kỳ cọ thật kỹ trong vòng 1 phút, cuối cùng dùng nước nóng rửa sạch xà phòng. Tiếp đó, tác giả lấy mẫu nước trong bồn để đem soi dưới kính hiển vi.
Kết quả cho thấy rằng những ngày đầu tiên phần nước này rất sạch sẽ, không có dấu hiệu của vi khuẩn. Tuy nhiên sau đó, vi khuẩn bắt đầu xuất hiện, sinh sôi rất nhanh. Ước tính chỉ từ 20 đã sinh sôi lên đến số lượng 45.000 con vi khuẩn trong vòng 10 ngày. Cuối video, tác giả nhận định bồn rửa dù cho đã sử dụng nước nóng và xà phòng thì cũng chưa thể sạch được hoàn toàn.
Ước tính chỉ từ 20 đã sinh sôi lên đến số lượng 45.000 con vi khuẩn trong vòng 10 ngày. (Ảnh cắt từ clip).
Theo PGS.TS Nguyễn Duy Thịnh (nguyên giảng viên Viện Công nghệ thực phẩm, trường Đại học Bách Khoa, Hà Nội): Việc bồn rửa dù đã cọ bằng xà phòng hay nước nóng mà vẫn còn vi khuẩn là hoàn toàn có thể xảy ra. Bởi để tiêu diệt vi khuẩn chúng ta phải dùng nước 100 độ C, trong khi đó nước nóng ở vòi chưa đủ nóng đến mức đó. Tuy rằng quá trình cọ rửa có thể tiêu diệt một phần vi khuẩn nhưng chưa chắc đã tiêu diệt được toàn bộ. Hơn nữa, vi khuẩn trong bồn có thể xuất hiện trở lại do dụng cụ cọ rửa không đủ sạch, hoặc vi khuẩn lây lan từ ống rác...
"Trong bồn rửa chỉ cần xuất hiện vài con vi khuẩn thì sau vài giờ nó đã phát triển cực nhanh, theo cấp số nhân. 1 thành 10, 10 thành 100, 100 thành 1000, do đó việc vệ sinh bồn rửa mà chưa đảm bảo rằng phần túi rác trong bồn đủ sạch sẽ... thì khả năng nhiễm khuẩn chéo chắc chắn xảy ra", vị chuyên gia cho hay.
Theo các chuyên gia, chỉ dựa vào nước nóng hay xà phòng thì không thể khẳng định bồn rửa sẽ sạch hoàn toàn. Thay vào đó, mọi người nên sử dụng sản phẩm tẩy rửa chuyên dụng dành cho nhà bếp. Hơn nữa, bồn rửa nên được cọ sạch ngay sau mỗi lần nấu. Nếu để lâu, các vết bẩn càng trở nên cứng đầu, khó tẩy sạch và càng dễ tích tụ vi khuẩn hơn. Ngoài vệ sinh bồn rửa, những vật dụng như bàn chải nhà bếp hay giẻ lau bếp, miếng xốp rửa bát cũng cần phải thay mới đều đặn 1 tháng một lần để tránh việc chúng lây lan vi khuẩn sang môi trường nấu ăn.

Nhiều chuyên gia khuyên rằng, nên sử dụng chậu riêng để rửa thực phẩm thay vì ngâm trong bồn rửa bát, cho dù trước đó đã vệ sinh bồn kỹ càng đến mức nào.
Quy trình vệ sinh bồn rửa đúng chuẩn mọi gia đình nhất định phải biết
- Bước 1: Dọn sạch rác trong chậu rửa, bát lọc rác
Việc đầu tiên trước khi muốn vệ sinh chậu rửa bát, bạn cần phải đổ hết rác và loại bỏ cặn bẩn trong rổ đựng rác của chậu rửa, kể cả những thứ rác nhỏ bám xung quanh chậu. Sau đó, sử dụng bàn chải đánh răng cọ rửa sạch những cặn bẩn bám trên rổ rác.
- Bước 2: Cọ rửa và làm sạch vòi rửa, cần rửa
Cần rửa và vòi rửa ở phía trên ít bám bẩn dầu mỡ hơn nhưng hằng ngày số lần chúng ta sờ, chạm tay vào chúng cũng rất nhiều nên các bà nội trợ lưu ý không được bỏ sót vệ sinh những khu vực này.
- Bước 3: Cọ rửa chậu và thành chậu
Chỉ cọ rửa bằng nước sạch và xà phòng thôi chưa đủ để có thể tiêu diệt hết mọi vết bẩn và vi khuẩn trong chậu rửa. Sẽ hiệu quả hơn nếu bạn sử dụng thêm miếng bọt biển hoặc miếng rửa bát làm từ sợi ráp. Đối với những ngóc ngách khó rửa, bạn có thể dùng bàn chải đánh răng cọ kỹ để vết bẩn biến mất.
Thay vì dùng xà phòng, bạn có thể dùng hỗn hợp baking soda; hoặc dùng muối + chanh; hoặc dùng hỗn hợp muối, giấm và nước nóng... đây đều là những chất tẩy rửa từ thiên nhiên có độ an toàn cao, hiệu quả tốt.
Cuối cùng, sau khi đã làm sạch tất cả, bạn hãy đổ nước sôi vào bát lọc rác và toàn bộ chậu rửa, cống sẽ không còn tắc, mùi hôi không còn nữa mà chậu rửa đã được khử trùng sạch sẽ, sáng bóng.
Theo Phụ Nữ Việt Nam